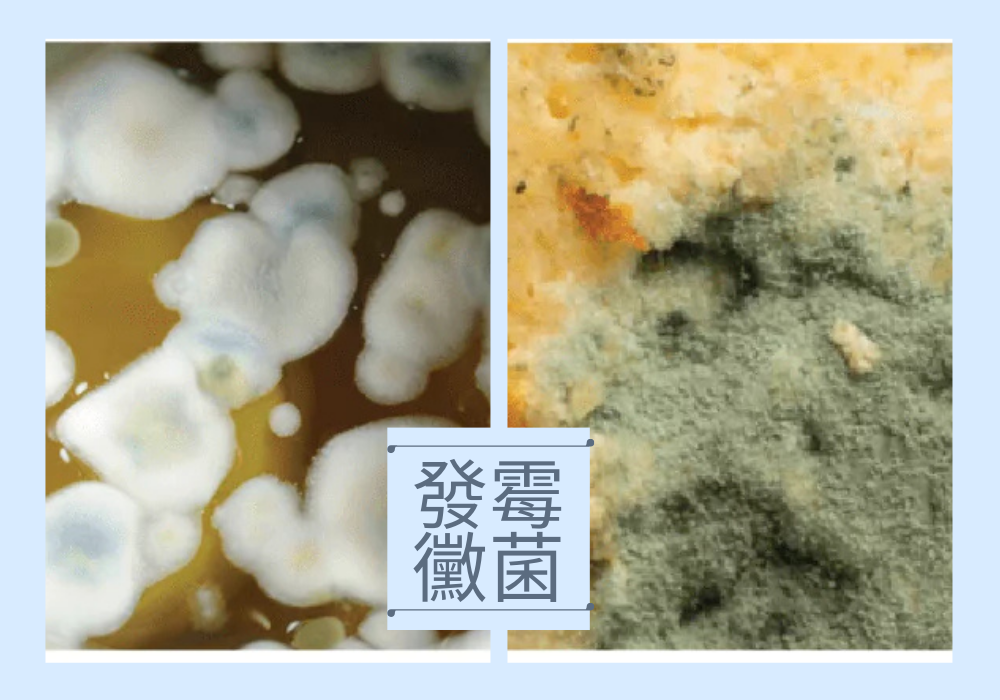

Fermentation is a rewarding and fascinating process, but it can also raise questions, especially when you notice unfamiliar changes on the surface of your fermented food or drink. A common concern is whether it is still safe to consume or if it should be discarded.
Let’s start with an important reminder: Not all formations on the surface of fermented foods are harmful.
Not Every Surface Formation Means Mold
During fermentation, changes in temperature, air exposure, or fermentation time can cause visible changes on the surface. In most cases, these are normal by-products of fermentation. Only in rare situations does true mold develop.
One of the most commonly misunderstood formations is Kahm yeast
What Is Kahm Yeast?

Kahm yeast usually appears as a thin, white or creamy film on the surface of fermenting liquids such as kefir, kombucha, or lacto-fermented vegetables.
As lactic acid bacteria consume sugars, they produce lactic acid, creating an acidic environment. This acidity helps prevent harmful bacteria from growing while allowing Kahm yeast to form naturally.
✔ Kahm yeast is not harmful
✔ It is a natural part of fermentation
✔ Its presence does not mean the product has gone bad
Fermentation is a highly dynamic process involving living microorganisms. These microorganisms have evolved ways to adapt to environmental changes, helping maintain stable and successful fermentation. Kahm yeast is one such adaptation, acting as a protective mechanism during the fermentation process.
What Is Mold?
Molds are a type of fungus that can grow on food and beverages. They are multicellular organisms and are usually easy to identify by their fuzzy, powdery, or hairy appearance. Mold can appear in various colours, including green, black, grey, or blue, and often produces an unpleasant, musty smell.
⚠️ If mold is present, the entire ferment should always be discarded.
Kahm Yeast vs. Mold: Key Differences
| Feature | Kahm Yeast (Normal) | Mold (Unsafe) |
|---|---|---|
| Appearance | Thin, white or creamy film | Fuzzy or powdery, various colours |
| Texture | Smooth and flat | Cottony, hairy, or raised |
| Growth Pattern | Stays on the surface | Can penetrate deeper into the product |
| Smell | Mild, slightly sour | Musty or unpleasant odour |
- White, flat, film-like layers are usually a normal fermentation occurrence
- Colourful, fuzzy, or raised growth indicates mold and should not be consumed





